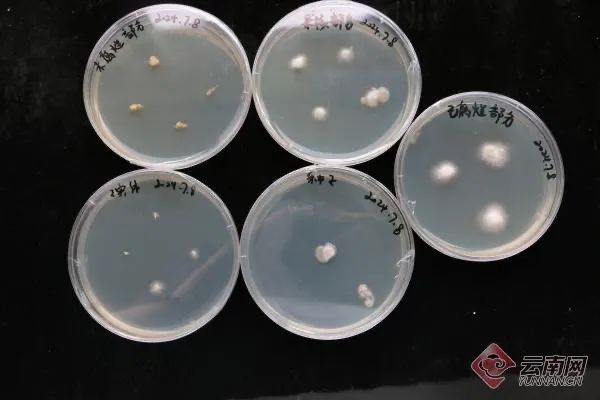
继“果菌王”之后，“蒜什蘑”也来到了昆明……

前段时间,浙江网友将自家“长蘑菇”的苹果赠送给中国科学院昆明植物研究所作进一步研究一事引发众多网友的关注和讨论。→苹果上长菌,昆明专家千里求购!网友:这菌会有苹果味吗?
近日,中国科学院昆明植物研究所又收到了四川泸州一名网友寄来的长蘑菇的大蒜,不少网友调侃“蘑菇也开始装蒜了?”还有网友为它取名“蒜什蘑”。

中国科学院昆明植物研究所科研人员。@菌罗万象视频截图
视频中,科研人员在收到“蒜什蘑”后第一时间就展开初步的研究,“大蒜内部已经腐烂,菌丝长到了蒜瓣上,在外面形成了一个子实体。”科研人员用刀切开网友寄来的大蒜并介绍,此次的蘑菇与“果菌王”一样同为裂褶菌(白参)。
此前科研人员从苹果不同部位分离出来的菌丝
在“蒜什蘑”的“开箱视频”下,有网友晒出长出蘑菇的牛油果,中国科学院昆明植物研究所科研人员 @菌罗万象 立马回复:“要要要”。从“果菌王”到“蒜什蘑”,为什么会有这么多“神奇水果”?研究这些“神奇水果”又有什么价值?

对此,中国科学院昆明植物研究所真菌多样性与分子进化课题组许博士此前在“果壳”公众号采访中回应称,尽管这是一株普通的白参,但它在这种非传统基质上的生长表现,展现了白参极强的适应性和生命力。这不仅提供了关于白参环境适应性的新见解,为后续的菌种选育工作提供了很大的可能性。“同时,这项试验也可能对种植业带来新的洞察——我们可以评估这种真菌是否会对商业果树种植构成潜在风险,又或者真的能够研发出带有其他风味的白参。虽然这种可能性较小,但该探索为理解菌类和植物之间复杂的互动提供了宝贵的视角。”许博士说。
此前,许博士所在团队就曾在中国科学院昆明植物研究所正高级工程师赵琪的带领下,将包括羊肚菌、黑牛肝菌、金耳、白参等云南高原特色食、药菌菌种通过神舟十二号、十四号、十六号载人飞船送入太空。
“育种不是一蹴而就的事,只有经历一代代的选育,才能种出产量更高、更适宜菇农采摘、口感更好的蘑菇,这也是我们一直努力的目标。”赵琪表示。
云南网记者:杨苑 张琦敏


点击右上角![]() 微信好友
微信好友
 朋友圈
朋友圈

点击浏览器下方“ ”分享微信好友Safari浏览器请点击“
”分享微信好友Safari浏览器请点击“ ”按钮
”按钮

点击右上角 QQ
QQ

点击浏览器下方“ ”分享QQ好友Safari浏览器请点击“
”分享QQ好友Safari浏览器请点击“ ”按钮
”按钮
